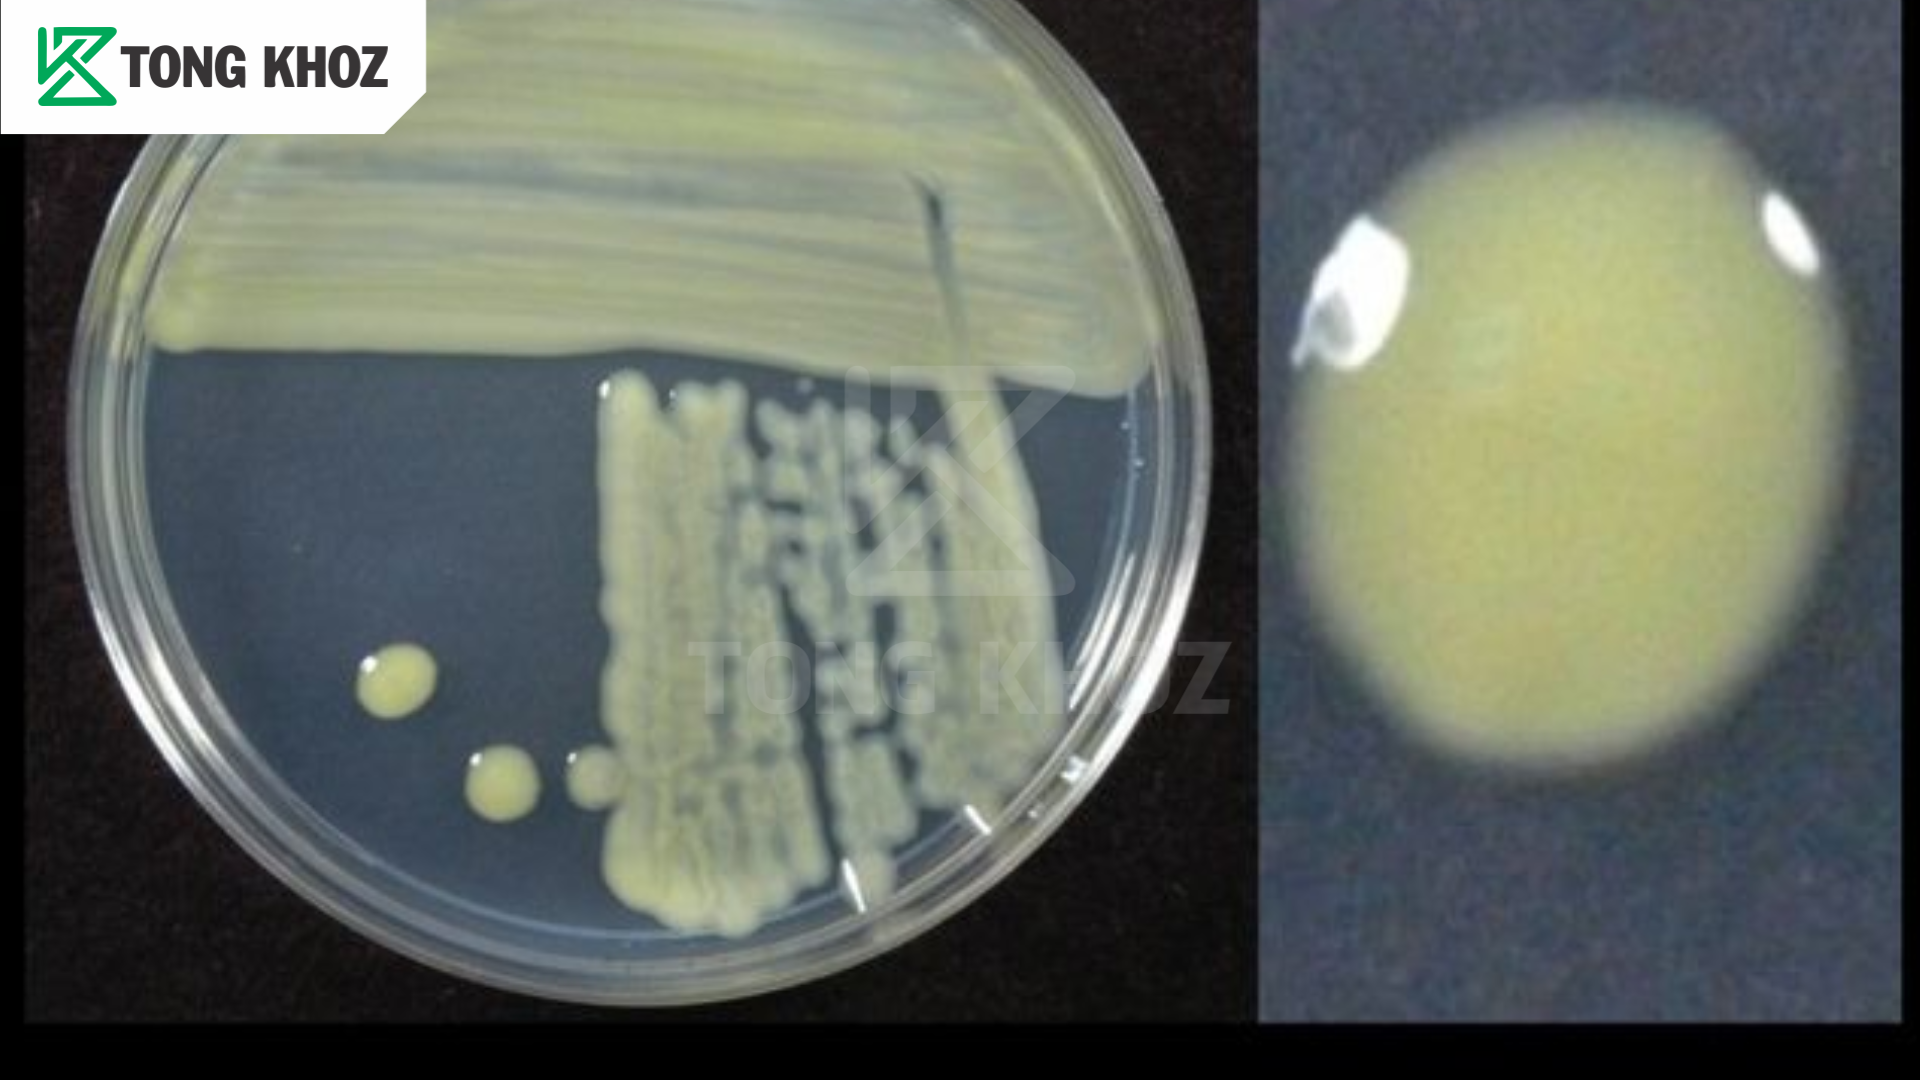

Bệnh cháy lá bắp cải là một trong những bệnh hại phổ biến nhất trên rau họ cải, gây ảnh hưởng lớn đến năng suất và chất lượng. Bệnh thường xuất hiện trong điều kiện thời tiết nóng ẩm, mưa nhiều hoặc khi cây bị chăm sóc kém, bón phân mất cân đối. Khi nhiễm bệnh, lá bắp cải bị cháy vàng, khô mép, thậm chí rách nát, làm cây còi cọc và khó cuộn bắp. Bài viết này, Tổng Kho Z sẽ giúp bà con tìm hiểu nguyên nhân, triệu chứng và biện pháp phòng trừ bệnh cháy lá bắp cải hiệu quả.
1. Nguyên nhân gây bệnh cháy lá bắp cải
– Bệnh cháy lá bắp cải chủ yếu do vi khuẩn Xanthomonas campestris gây ra. Đây là loại vi khuẩn nguy hiểm, có thể tồn tại lâu trong đất và tàn dư cây bệnh.
– Nguồn bệnh lưu giữ trong đất, nước tưới, cỏ dại ký chủ phụ và trên dụng cụ canh tác chưa khử trùng.
– Vi khuẩn thường xâm nhập vào cây thông qua vết thương cơ giới, vết cắn côn trùng hoặc các giọt nước đọng trên lá.
– Thời tiết nóng ẩm, mưa nhiều, ruộng thoát nước kém tạo điều kiện lý tưởng cho vi khuẩn phát triển.
– Ruộng trồng dày, bón phân không cân đối, dư đạm cũng khiến cây yếu, dễ nhiễm bệnh.
– Vi khuẩn có tốc độ lây lan nhanh, đặc biệt khi có gió, mưa to làm nước bắn sang cây khỏe.
– Một khi đã xâm nhập, chúng phát triển trong mô lá, phá vỡ tế bào, tạo ra vết cháy loang lổ trên lá bắp cải.
2. Triệu chứng bệnh cháy lá bắp cải
– Vết bệnh xuất hiện đầu tiên ở mép lá, có màu nâu sẫm với viền vàng bao quanh.
– Hình dạng vết bệnh thường giống chữ V, mũi nhọn hướng vào giữa phiến lá.
– Khi vi khuẩn phát triển mạnh, vết bệnh lan sâu vào trong lá.
– Lá dần chuyển vàng, gân lá sẫm màu, phần bị bệnh thối nhũn và rụng.
– Ban đầu chỉ là những đốm nhỏ màu nâu hoặc đen, sau lan rộng.
– Vết bệnh có thể chuyển sang xám trắng với viền nâu đậm.
– Vùng lá bị bệnh thường khô, teo lại, dễ rách và biến dạng.
– Bệnh có khả năng lây lan nhanh từ lá già sang lá non.
– Cây bị bệnh nặng có thể yếu đi, thậm chí chết nếu không xử lý kịp thời.
3. Tác hại của bệnh cháy lá bắp cải
– Bệnh làm lá bắp cải cháy khô, vàng úa và dễ rụng sớm.
– Giảm khả năng quang hợp, cây còi cọc, chậm phát triển.
– Bắp cải khó cuộn bắp, năng suất và chất lượng đều giảm.
– Lá bị cháy loang lổ, rau mất thẩm mỹ, khó tiêu thụ.
– Nông dân tốn thêm chi phí thuốc và công chăm sóc.
– Bệnh lây lan nhanh, có thể gây hại trên diện rộng.
– Nếu không xử lý kịp thời, ruộng bắp cải có nguy cơ mất trắng.

4. Biện pháp phòng trừ bệnh cháy lá bắp cải
4.1. Biện pháp canh tác
– Chọn giống bắp cải khỏe, có khả năng kháng bệnh tốt.
– Trồng với mật độ vừa phải, giữ ruộng thông thoáng.
– Luân canh với cây khác họ, không trồng cải liên tục.
– Bón phân cân đối, không lạm dụng phân đạm.
– Vệ sinh đồng ruộng, dọn sạch tàn dư cây bệnh.
– Tưới nước hợp lý, tránh để ruộng úng nước kéo dài.
4.2. Biện pháp sinh học
– Sử dụng chế phẩm vi sinh chứa Trichoderma để ức chế nấm bệnh.
– Dùng Bacillus subtilis giúp hạn chế vi khuẩn gây bệnh cháy lá.
– Kết hợp bón phân hữu cơ hoai mục, bổ sung chế phẩm phân giải.
4.3. Biện pháp hóa học
– Phun thuốc ngay khi bệnh mới xuất hiện để đạt hiệu quả cao.
– Luân phiên hoạt chất để tránh kháng thuốc.
– Một số hoạt chất hiệu quả: Mancozeb, Chlorothalonil, Copper hydroxide, Azoxystrobin,….
– Tuân thủ nguyên tắc 4 đúng và thời gian cách ly trước thu hoạch.
5. Câu hỏi thường gặp về bệnh cháy lá bắp cải
1. Bệnh cháy lá bắp cải do nguyên nhân nào gây ra?
--> Bệnh chủ yếu do vi khuẩn Xanthomonas campestris, ngoài ra có thể do nấm và điều kiện thời tiết bất lợi.
2. Bệnh cháy lá bắp cải thường xuất hiện khi nào?
--> Bệnh phát triển mạnh vào mùa mưa ẩm, nhiệt độ cao, ruộng thoát nước kém.
3. Triệu chứng sớm của bệnh cháy lá là gì?
--> Lá xuất hiện đốm nâu viền vàng, thường có dạng chữ V hướng vào phiến lá.

Bệnh cháy lá bắp cải là một trong những dịch hại phổ biến và nguy hiểm, ảnh hưởng trực tiếp đến năng suất và chất lượng rau. Nếu không phòng trừ kịp thời, bệnh có thể lan rộng và gây thất thu nặng nề. Để quản lý hiệu quả, bà con cần kết hợp đồng bộ các biện pháp: canh tác hợp lý, sử dụng chế phẩm sinh học và áp dụng thuốc BVTV đúng cách.
LIÊN HỆ TƯ VẤN MIỄN PHÍ
TỔNG KHOZ – PHÂN BÓN CHÍNH HÃNG, GIÁ RẺ
Địa chỉ: Số 68, Nguyễn Huệ, Phường Sài Gòn, TP.HCM
Hotline Kinh Doanh: 0856.77.66.99 – Hotline Kỹ Thuật: 085555.99.44
Trang web: Tổng KhoZ
Email: tongkhoz@gmail.com
Facebook: Tổng KhoZ